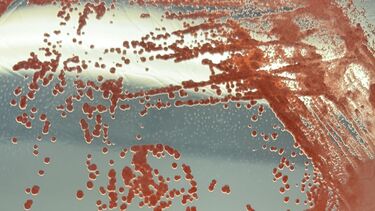
Petri dish

Turning toxic liquids into sustainable materials
Domestic and industrial activities produce millions of tonnes of waste, and even buried waste leaks pollutants that carry environmental risks. But by combining microorganisms with different capabilities, Sheffield researchers are turning harmful liquid into useful resources.

Human activities, from industrial manufacturing to home life, create substantial volumes of waste every year. Wastewater is treated, but when it is landfilled, a large amount of waste-contaminated water, known as leachate, is created.
These harmful liquids carry toxic chemicals and heavy metals that can contaminate soil and water, posing a threat to the environment and human health.
But while waste streams are either foul or toxic to humans, Sheffield researchers have discovered that they can provide essential nutrients for specific microorganisms to live on. Bacteria and microalgae can work together to consume poisonous chemicals and convert them into metabolic products, many with industrial potential.
Professor Jagroop Pandhal from the School of Chemical, Materials and Biological Engineering at the University of Sheffield and his team are leading research on microbial systems engineering methods to convert components in different wastewaters into useful biochemicals.
Funded by multiple research councils within UKRI, InnovateUK, private industries, as well as other international sources such as the US Department of Energy, their work is at the forefront of understanding the mechanisms of these microbial systems and harnessing them for environmental benefits.
Some of these microbial systems have developed intricate natural interactive relationships through co-evolution. At a basic level, as bacteria digest toxic organics, the resulting CO2 is taken up by microalgae for photosynthesis, which produces oxygen.
The bacteria consumes O2 whilst respiring, gaining energy to degrade pollutants further. However, some interactions are more complex. Understanding these mechanisms will allow scientists to mimic such systems, or develop new functional traits and harness them for environmental benefits.
The challenge is selecting the right strains to form consolidated communities.
By combining knowledge from microbiologists, chemical engineers, and modellers, we can design better systems and understand how to bring microbes together for various purposes.
Professor Jagroop Pandhal
Professor of Microbial Systems Engineering
In the early phase of the research, the Pandhal Research Group looked at the pollution caused by household waste disposal.
A common method to treat waste materials is by burying them in landfill sites. Known as leachate, the downstream drain from landfilling contains high concentrations of hazardous matters, including ammonia, dissolved and suspended organics, inorganic chemicals, and heavy metals.
To find species that could grow faster in the liquid waste, researchers at Sheffield spent two years culturing algae and bacteria isolated from leachate ponds near Sheffield.
High ammonia content is one primary factor that suppresses microbes. Over 24 months of evolution in different mediums, the consortia developed traits that could adapt to the harsh conditions and thrive in the waste stream.
Sheffield researchers demonstrated the capability for this consortia to grow on leachate in a 400 L serpentine photobioreactor, a piece of equipment based outside the Arthur Willis Environment Centre (AWEC) at the University that provides the ideal conditions for phototrophic microorganisms to grow.
Bringing research from the lab to industry
The interactions in the co-evolved consortia have since been characterised, providing insight into how microbes can be combined for growth on different waste streams. Also, the process took years and is therefore relatively time-consuming in terms of industrial applications. Now, the researchers have developed new methods for bottom up design of consortia, identifying “keystone” species.
An efficient alternative is a screening approach. Researchers have collected bacteria and algae from a site that is exposed to volatile organic compounds (VOCs) pollution, creating different combinations and testing their degradation capability. They compared more than 700 combinations over a couple of months and developed three new indices that can describe consortium functionality and stability.
Moreover, to speed up the process, it is important to select well studied strains and genetically engineer traits that enhance symbiosis. Using synthetic biology principles, scientists are able to create artificial consortia, and the Pandhal group have worked with autotrophic strains that share organic forms of nitrogen and carbon, this means they can grow with just air, water, phosphate and a few trace elements.
The improved techniques of the Sheffield team enabled the work on a wide range of harmful substances including greywater, industrial effluent and hydrocarbons.
In collaboration with companies such as Sony, Viridor and Freeland Horticulture, the Pandhal research group sources industrial waste streams, mostly liquid, but also gaseous, and develops microbial consortia that deal with a variety of waste streams. However, collaborations with researchers who perform downstream processes to harvest cells, and extract and separate valuable biochemical components is a vital part of many of the projects. Performing techno economic analyses on these also highlights where further optimisations are required.
Shifting to a circular microeconomy
But the work doesn’t stop there. The team's ambition goes beyond the protection of human health and the environment and sets on the agenda the recovery of natural resources. The biomass resulting from bioprocessing can be recycled as raw materials for green manufacturing.
"Our main goal is to convert waste into a feedstock for the microbes. As they grow, they'll degrade various toxic organic compounds and transform them into non-toxic biomass, and by tuning cultivation parameters, we can promote the production of biochemicals we want to extract. The overall process creates biomass that can be converted into various useful bio-products" explains Professor Pandhal.
"We’re now harvesting more products from diversified strains, including fatty acids, cellulose and other materials. Further processing can transform them into treasures, such as fuel, feed, biodegradable plastics, coating, films and bioactive molecules, generating economic benefit" adds Professor Pandhal.
Most species have been isolated in nature and now hold the potential to significantly change the environment when human activities are profoundly changing the climate and ecosystem. Algae-bacteria interactions are consortia but have evolved over millennia, so there is a large opportunity to exploit their metabolic capabilities for promoting a circular economy, and changing the next generation of industry.
“The term microbiome is being increasingly used in health and medicine, however, if we can engineer environmental algal-bacteria microbiomes for industry, we can envisage a much greener and sustainable future”, adds Professor Pandhal.
For further information please contact: mediateam@sheffield.ac.uk